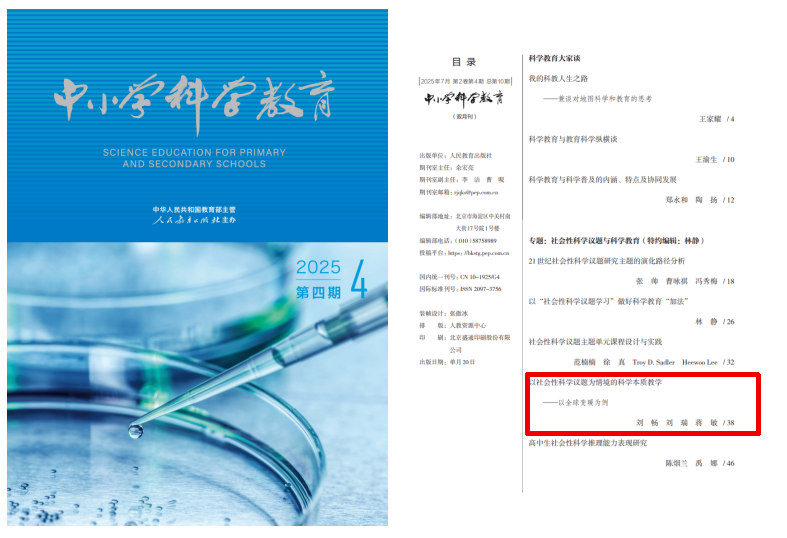
1.png

北京师范大学社会性科学议题学习项目研究成果
文章标题:以社会性科学议题为情境的科学本质教学——以全球变暖为例
作者:刘畅1刘瑞1蒋敏2
作者单位:1.四川师范大学化学与材料科学学院2.成都冠城实验学校部
本文来源:《中小学科学教育》2023年12期
摘要:科学本质作为国际科学教育的重要目标,在对社会性科学议题决策的探讨中发挥着重要的作用,但目前缺乏科学本质教学的材料和范例。采用“显性-反思性”科学本质教学,通过提问显性化和活动反思,能有效提升对科学本质的理解。社会性科学议题兼具科学性和社会性,为学生参与和讨论科学本质提供真实情境。“全球变暖”这一案例通过展示“危机”与“骗局”两种观点的数据,再利用指向科学本质的问题组引发学生讨论和反思,引导其进行决策与辩论,最终讨论应对全球变暖采取的措施及成效。
基金: 四川师范大学“虚拟教研室”建设项目(XJ20211234);
在过去的一个世纪,科学本质(nature of science)一直是国际科学教育的重要目标。[1]科学本质能够回答科学是什么、科学是如何运作的、科学家是如何工作的以及社会是如何影响和反映科学事业的。[2]理解科学本质不仅可以促进学生对科学知识的学习,帮助其理解日常生活中的科学和技术问题,还是其作为一个合格公民参与社会决策所需要的。[3]研究表明,学生对科学本质的理解是不充分的,并且在很多方面存在迷思。[4]为提高学生的科学本质观,当前相关研究致力于探索有效的科学本质教学。研究表明,社会性科学议题(socio-scientific issues,SSI)蕴含丰富的科学本质内容,能为学生参与和讨论科学本质提供机会,为有效的科学本质教学提供良好情境。[3]在社会性科学议题情境中进行科学本质教学,对于发展学生“科学态度与责任”核心素养、促进学生以理性的态度参与社会决策起到重要作用。
我国自 2001 年基础教育课程改革以来, “科学本质”作为关键词出现在科学领域各学科的课程标准中。《普通高中化学课程标准(2017 年版)》和《义务教育化学课程标准(2022 年版)》要求“增进对科学本质的理解”[5]“引导学生认识科学本质”[6]。尽管课程标准强调了科学本质的重要性,但缺乏对其内涵和维度的明确阐述,以及对如何有效开展科学本质教学的指导。同时,教师也缺乏科学本质教学的材料和范例。当前,全球变暖的媒体报道层出不穷,已成为学生熟知的热门话题。初中化学多个版本教科书中均有全球变暖的相关章节。基于此,本文探讨以社会性科学议题为情境的科学本质教学的概念和理论,呈现全球变暖情境下实施科学本质教学的过程、 痕 迹(tricky tracks)、立方体(the cubes)等。[8]素材和策略,以期丰富有效科学本质教学的相关理论,并为教师开展科学本质教学提供参考。
一、以社会性科学议题为情境的“显性-反思性”科学本质教学
(一)“显性 - 反思性”是有效科学本质教学的核心
科学本质被认为是学生难以理解的内容,教授科学本质对教师来说是一项具有挑战性的任务。有效科学本质教学的研究经历了从“隐性”到“显性-反思性”的发展过程。20世纪60—70年代,研究者主要采用“隐性”方法教授科学本质,认为学生可以在动手做等探究活动中自发地理解科学本质。在“隐性”教学中,教师通常将科学本质作为教学活动的“副产物”,缺乏有意识的科学本质教学,学生也没有关注到教学活动中的科学本质。大量研究表明,“隐性”教学无法有效提高学生对科学本质的理解。[1]
20世纪90年代以来,“显性-反思性”教学逐步确立为有效的科学本质教学方法。“显性”的意思是:科学本质的教学不应是说教式,而应通过提问吸引学生对科学本质的注意,有目的地让学生关注到教学中的科学本质。这里的“有目的”凸显了与“隐性”科学本质教学的不同,即科学本质不是其他教学活动的“副产物”或附带的情感性目标,而是与科学内容同样重要的认知性目标。[7]“反思性”是指教师帮助学生有意识地反思自己对科学本质的已有认知,并通过交流、讨论等活动发展学生对科学本质的理解。
“显性-反思性”科学本质教学可以分为“去情境化”和“情境化”的学习活动。“去情境化”学习活动是在与科学无直接相关的活动中进行科学本质教学,如黑箱(black box)、痕 迹(tricky tracks)、立方体(the cubes)等。[8]其中,“黑箱”活动通过让学生根据输入(如倒入无色液体)和输出(液体变色)现象推测黑箱内部结构;“痕迹”活动借助脚印分布图,引导学生区分直接观察(如脚印形状)与逻辑推论(如动物行为);“立方体”活动则通过限制视角的立方体观察任务,促使学生通过证据共享和逻辑推理合作解决科学问题。这类活动将学生的注意力集中到科学本质上,不易受到复杂的科学内容或情境的干扰,但由于缺乏与科学的相关性,学生较难将自己的活动与科学建立联系。“情境化”学习活动将科学本质与科学内容或情境相结合。Lave 和 Wenger 的工作为理解科学本质教学与情境之间的联系提供了理论依据,即学习不能脱离它发生的环境而单独实现,当学生在真实的情境中学习科学本质时,更有可能将对科学本质的理解整合到他们的认知中。[9]研究表明,社会性科学议题为增进学生对科学本质的理解创造了良好的情境,有助于合理判断和明智决策。[10]
(二)社会性科学议题为科学本质教学提供了良好的情境
社会性科学议题是指与科学相关的、开放性的、结构不良的、涉及多种观点和解释的社会问题。[11]随着科学与社会生活的高度融合,社会性科学议题愈发增多,比如全球变暖、转基因食品、汽车限行、电子烟监管等。将社会性科学议题引入课堂,可将课堂转化为学生参与决策的实践社区。[12]以社会性科学议题作为科学本质的教学情境,学生可以意识到“发展中的科学”的关键方面[13],比如暂时性、实证性、主观性和社会文化嵌入适配性等。同时,引导学生将对科学本质的理解应用于社会性科学议题的真实辩论中,培养其作出明智决策的能力,进而提高他们的公民素养。
社会性科学议题具有科学性和社会性,有利于学生对科学和社会之间的相互影响进行思考。[7]首先,社会性科学议题的解决方案往往是开放且复杂的,无法完全依靠科学来决定。科学理论或科学数据可为议题决策和解决方案提供信息,但决策和解决的过程受到政治、经济、伦理、道德等各种社会因素的影响。因此,在参与社会性科学议题讨论和作出决策时,还需要思考议题所涉及的社会方面,例如经济利益和道德伦理等。其次,社会性科学议题具有争议性,学生在争论中能够显露他们对科学本质的理解。这有助于教师发现学生对科学本质理解不充分的方面,以便针对性地进行科学本质教学和互动。最后,社会性科学议题通常与学生的日常生活相关,更能引起学生的兴趣,激起学生积极的讨论,促进学生发表自己的看法。社会性科学议题情境可以为学生创造出许多讨论和反思科学本质的机会,让学生分析不同的科学观点,允许学生批判性地评价,讨论和辩论科学主张,促进参与和决策。聚焦科学本质,采用“显性-反思性”教学,以问题为导向,在互动和讨论社会性议题的过程中,将学生的价值观和社会规范与科学和技术建立联系,为促进学生理解科学本质创造了良好的情境,有助于促进学生反思和改进自己的科学本质观。
二、在全球变暖议题中进行科学本质教学
近年来,全球变暖被大众媒体争相报道,已经成为一个学生耳熟能详的热门话题。然而,在教科书中一般只提供全球变暖的一种观点,即全球变暖是人类活动释放的大量二氧化碳造成的,并对人类造成了巨大的威胁。事实上,关于全球变暖,科学界一直存在争论[14],有一种观点认为全球变暖与人类活动没有直接关系,而是地球温度周期性变化的自然现象。本案例根据相关文献准备了两种观点的教学材料供学生讨论关于全球变暖议题的争议性观点,在此基础上运用“显性-反思性”教学促进学生对科学本质的理解。具体教学设计流程见图 1。
(一)初步认识议题
在教学之前,教师播放有关全球变暖的视频《不容忽视的真相》。通过展示全球变暖的媒体报道,使学生意识到全球变暖是一个广受关注的议题。为帮助学生建立探讨全球变暖议题的知识基础,首先与学生共同讨论“为什么地球会具有适宜人类居住的温度?”引出“温室效应”。随后,教师补充讲解温室效应的相关内容:如果没有大气层,地表平均温度就会下降到 -23 ℃,而实际地表平均温度为15 ℃,这就是说温室效应使地表温度提高38 ℃。金星的大气层很厚,地表温度至少400 ℃,火星的大气层很薄,地表温度大约-63 ℃。通过对比地球、金星、火星的温室效应,理解温室效应与地球气温的关系。
提问“大气层中有哪些主要的温室气体”,引出学生在温室气体方面的已有知识,学生回答:二氧化碳、氟利昂、甲烷等。教师补充水蒸气在温室效应中的重要作用——温室效应有 75%是水蒸气的作用[15],但大气中的水蒸气的含量通常不能直接由人类活动改变。
通过学习温室效应及其与地球气温的关系、温室气体的作用和组成等,帮助学生建立理解全球变暖议题的知识基础。

(二)厘清全球变暖的两种争议性观点
全球变暖一直是一个争议性的议题,科学家对全球变暖有两种不同的观点。教师展示两种不同观点的科学简报(“危机”/“骗局”),学生了解并讨论关于全球变暖的两种争议性观点,为接下来的科学本质教学创设真实情境。
简报1:全球变暖的“危机”
下图为近 100 年地球平均温度变化曲线(图2)和80万年间二氧化碳和温度的变化曲线(图 3)。人类燃烧煤炭、石油、天然气等燃料释放了大量的二氧化碳,因此全球变暖是人类活动造成的。科学家用计算机模拟预测了一场由全球变暖带来的大范围的环境灾难:全球变暖使冰川融化,这将导致海平面上升。上升的海洋将淹没世界上数百万亩的沿海地区。生态变化还将使不计其数的动物和植物灭绝。那些反对全球变暖的科学家是受了石油和汽车企业的资助,这些企业要保护他们自己的经济利益。减少温室气体(如二氧化碳)的排放会花费大量资金,但是如果不减少的话,环境恶化的成本将会远远超过任何企业或个人的损失。


这种观点和大众媒体的报道一致,认为全球变暖是人为排放二氧化碳造成的,并使人类面临着一场危机,我们称其为“全球变暖的危机”。根据图 2 的气候数据图,在过去 100 年间(1920—2020),地球平均温度上升了大约1.20 ℃。图3展示了二氧化碳浓度和地球温度的关系。小组讨论,对这一关系图进行解释。受刻板印象的影响,学生会认为图3表明,随着地球上二氧化碳含量增加或减少,地球温度也相应升高或降低。
简报2:全球变暖的“骗局”
给出 1000 年来地球平均温度变化曲线(图 4),以及与图 3 相同的 80 万年间二氧化碳和温度的变化曲线。减少煤、石油、天然气的使用将对全球经济造成重大的影响。工业会被抑制,国家经济会衰退,我们每个人也会遭受损失。
虽然“全球变暖的危机”反映了主流媒体的观点,但仍有部分科学家认为全球变暖是一场“骗局”。图 4 显示了 1000 年来地球平均温度的变化,科学家们认为,从历史上看,地球温度发生周期性变化是正常的。站在全球变暖是“骗局”的观点,学生会意识到,图3也可以解释为地球自身温度的变化引起了二氧化碳浓度的增加或减少(例如,地球自身温度升高会使冻土层中的温室气体大量释放)。这时可以要求学生对相同证据(图3)的两种不同解释进行讨论和反思。
(三)“显性 - 反思性”科学本质教学
“显性-反思性”教学通常可以具体化为教师提问和学生讨论。[19]当学生完成全球变暖的两种争议性观点材料的学习后,根据全球变暖的内容,教师提出指向科学本质的问题,引发学生讨论和反思。显性科学本质问题及教学目标见表1,这些问题可以通过改编,以适应其他社会性科学议题的科学本质教学。

基于社会性科学议题的争议性,通过显性科学本质问题,一方面,它可以揭示学生对科学本质的已有认知,另一方面,有助于引导学生建构更为充分的科学本质观。(1)对于“你认为哪种观点更科学”,有的学生认为“全球变暖的‘危机’”更具科学性,有的学生支持“全球变暖的‘骗局’”。当学生阐明其理由时便有可能暴露其判断科学性的标准。双方在争辩的过程中会发现无论支持哪种观点更具科学性,都需要从“科学以经验证据为基础”出发进行争论。(2)对相同的证据(图 3)为什么会得到不同结论的讨论,首先会引出学生对主观性科学本质的理解,如“知识经验不同、思考的方向不同或大脑不同”。再经过教师小结这些要素的共同特征——主观因素,帮助学生建构科学家对证据的解释受各种主观因素影响的科学本质。(3)对全球变暖的知识是否会发生改变和什么情况下会改变的讨论,将会引出学生对科学知识暂时性的观点,这时教师不应简单地接受“会改变”或“不会改变”的回答,而应注意引导学生平衡好科学知识的持久性与暂时性的关系,以免造成完全信任或完全不信任科学知识两种极端。(4)“你认为除了上面提到的证据,还有什么因素可能影响科学家对全球变暖的观点?”这一开放性问题引发了学生对全球变暖的广泛思考,如倾向于环保主义的科学家可能倾向将全球变暖视为“危机”,而持有不同观念的科学家可能对全球变暖的严重性持保留态度;如果大多数科学家认为全球变暖是“危机”,这种共识可能促使个别科学家重新评估自己的观点。最后教师总结并建构科学受社会、政治、经济、文化等因素影响的科学本质。
(四)做决策并阐述理由以反思科学本质
通过“你支持哪一种观点?”让学生作出自己的决策,并说明理由。这样做的目的是回归科学本质教育的主旨:面对社会性科学议题作出明智的决策,增强学生的参与意识与决策能力。进一步,教师需明确指导学生在社会性科学议题决策中运用科学本质。例如,“当你做决策时,是否考虑到某一观点所支撑的数据或者证据比较充足呢?是否会想到支持全球变暖是‘骗局’观点的科学家考虑到经济利益的影响呢?你在做决策时有考虑到其他方面的影响吗?”这些问题的目的是引导学生运用科学本质思考问题,并反思科学本质在决策中的应用。
然后,让学生反思总结此次决策的收获,加强学生对科学本质的进一步认识,强化决策与科学本质之间的联系。教师可以补充:“在科学与社会生活高度融合的今天,我们需要透过科学本质理解大众媒体对科学的报道,不能只凭主观猜测或者个人喜好去做决定,要更多地考虑某个观点是否有证据支持,证据和观点之间的论证是否充分,还要考虑一些其他因素,比如社会规范、道德准则、文化价值等,要以负责任的态度参与到社会性科学议题的决策中。”
(五)如何应对全球变暖
要引导学生认识到,数据显示全球确实在变暖,不论其根源是人类活动(简报1)还是自然因素(简报 2),我们都应该采取积极的措施来应对这一挑战。教师可以引导学生以负责任公民的态度多角度思考如何减缓全球变暖,并讨论各种可能的解决方案。学生可能已了解到目前我国已经采取了多项措施来减缓全球变暖,并取得了显著成效。教师可以向学生介绍我国“双碳”目标驱动能源转型的“新三驾马车”——光伏、锂电池和新能源汽车,它们为全球应对气候变化和绿色低碳作出了巨大贡献,降低了全球清洁能源使用成本,体现了负责任大国的担当。[20]
三、讨论与建议
(一)开发社会性科学议题情境素材
缺乏指向科学本质的教学材料是实施科学本质教学的重大挑战。[11]学生在日常生活或新闻媒体中接触到许多社会性科学议题,这为开展有效的科学本质教学提供了契机。教师应有意识地收集、整理和挖掘,使其成为科学本质教学的情境素材。社会性科学议题情境素材应涉及多种观点,能够引发辩论,提出多样化的解决方案,同时教师应注意呈现支持多种观点的证据,以及对证据的不同解释。情境素材还应与中学化学课程存在关联,这种关联可以是学科性的,还可以是跨学科的,如环境污染、可持续发展、资源利用等。教师可以从各种资源中搜集与化学相关的社会性科学议题,如新闻报道、科普书籍、学术期刊等。为了确保情境的有效性和质量,教师可以借鉴已有文献中的资源和案例,进行适当的修改和调整以适应教学需求,这对教师检索、筛选和阅读文献的能力提出了新的要求。
(二)建立科学本质与决策的联系
在科学与社会生活高度融合的今天,越来越多的社会性科学议题需要学生主动参与并作出明智的决策。社会性科学议题包含多方面科学本质,为科学本质教学提供了良好的情境。同时,科学本质的多维特征(如经验性、暂时性、主观性、社会文化嵌入性等)为学生理解复杂的社会性科学议题提供了思考框架。为此,教师应有意识地在科学本质与社会性科学议题之间建立联系,促进学生以理性的态度参与到社会性科学议题的决策中。基于社会性科学议题,提出与科学本质相关的问题,要求学生从认识论的视角审视有冲突的证据、相同数据的不同解释,结合影响决策的价值判断和社会规范,作出明智的决策。这样学生不仅能够深化对科学本质的理解,还能提升在复杂的决策环境中应用多维科学本质理性决策的能力。为了有效促进这一过程,教师可以组织角色扮演活动,让学生扮演科学家、政策制定者、利益相关者等不同角色。学生从不同的社会背景,从多维的科学本质视角去论证特定议题并进行决策或给出解决方案。[3]通过扮演不同的角色,学生能够体验到科学在多样社会情境中的应用和挑战。经历这些过程,学生更有可能发展自己的观点和决策能力,意识到科学本质对他们作出明智决策的作用。
参考文献
[1] ABD-EL-KHALICK F, BELL R L, LEDERMAN N G. The nature of science and instructional practice: Making the unnatural natural[J]. Science Education, 1998(4): 417-436.
[2] MCCOMAS W F, CLOUGH M P, ALMAZROA H. The role and character of the nature of science in science education[M]//MCCOMAS W F. The nature of science in science education: rationales and strategies. Dordrecht: Springer, 2002: 3-39.
[3] LEDERMAN N G, ANTINK A, BARTOS S. Nature of science, scientific inquiry, and socio-scientific issues arising from genetics: a pathway to developing a scientifically literate citizenry[J]. Science & Education, 2014(2): 285-302.
[4] DENG F, CHEN D T, TSAI C C, et al. Students’ views of the nature of science: a critical review of research[J]. Science Education, 2011(6): 961-999.
[5] 中华人民共和国教育部.普通高中化学课程标准(2017年版)[S].北京:人民教育出版社,2018:43.
[6] 中华人民共和国教育部.义务教育化学课程标准(2022年版)[S].北京:北京师范大学出版社,2022:51.
[7] KHISHFE R. Improving students’ conceptions of nature of science: a review of the literature[J]. Science & Education, 2023(6): 1887-1931.
[8] LEDERMAN N G, ABD-EL-KHALICK F, LEDERMAN J S. Avoiding de-natured science: integrating nature of science into science instruction[M]//MCCOMAS W F. Nature of science in science instruction: rationales and strategies. Cham: Springer, 2020: 295-326.
[9] LAVE J, WENGER E. Situated learning: Legitimate peripheral participation[M]. Cambridge: University of Cambridge Press, 1991.
[10] MCCOMAS W F, CLOUGH M P, NOURI N. Nature of science and classroom practice: a review of the literature with implications for effective NOS instruction[M]//MCCOMAS W F. Nature of science in science instruction: rationales and strategies. Cham: Springer, 2020: 67-111.
[11] SADLER T D CHAMBERS F W, ZEIDLER D L, et al. Student conceptualizations of the nature of science in response to a socio-scientific issue[J]. International Journal of Science Education, 2004 (4): 387-409.
[12] EASTWOOD J L, SADLER T D, ZEIDLER D L, et al. Contextualizing nature of science instruction in socioscientific issues[J]. International Journal of Science Education, 2012(15): 2289-2315
[13] MATKINS J J, BELL R L. Awakening the scientist inside: global climate change and the nature of science in an elementary science methods course[J]. Journal of Science Teacher Education, 2007(2): 137-163.
[14] 赖明东, 雍熙, 史文静. 全球变暖的解释模式:温室效应理论与气候的自然波动假说[J]. 自然辩证法研究, 2022(5): 69-74.
[15] Intergovernmental Panel on Climate Change (IPCC). Climate Change 2021: the physical science basis[M]. Cambridge: Cambridge University Press, 2023: 179.
[16] The National Aeronautics and Space Administration. Global Temperature [EB/OL]. [2024-04-24]. https://climate.nasa.gov/vital-signs/global-temperature/?intent=121.
[17] Time Scavengers. CO₂—past, present, & future [EB/OL]. [2024-04-24]. https://timescavengers.blog/climate-change/co2-past-present-future/.
[18] Intergovernmental Panel on Climate Change. Welcome to the IPCC Data Distribution Centre. [2024-04-24]. https://www.ipcc-data.org/.
[19] 李鹏源, 刘瑞, 赵亚杰, 等. “显性-反思性”的科学本质教学:以“原子结构”发展史为例[J]. 化学教育(中英文), 2020(1): 36-40.
[20] 李婕. 绿色产能不是多了,而是少了[N]. 人民日报海外版, 2024-04-29(1).